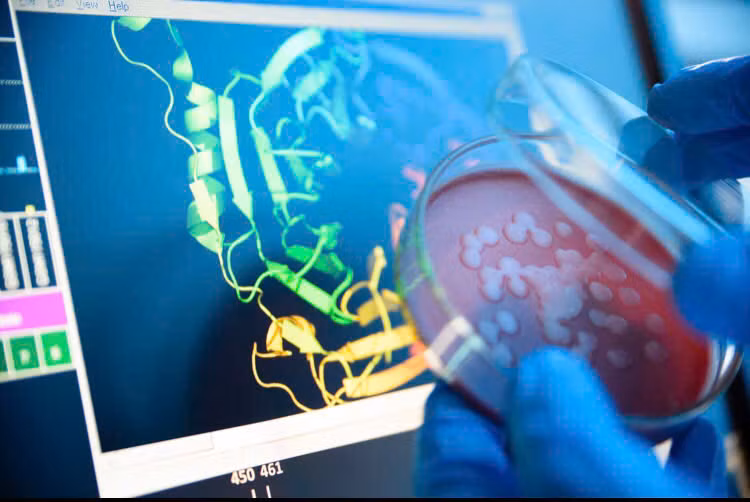
Trong một nghiên cứu được công bố đầu tháng 7/2024 trên cơ sở dữ liệu bioRxiv, các nhà khoa học đã sử dụng mô hình AI mới ESM3, để tạo ra một loại protein huỳnh quang mới chỉ chia sẻ 58% trình tự của nó với các protein huỳnh quang xuất hiện tự nhiên. (Ảnh: Quartz )

![[GALLERY] Sốc với doanh thu 300 triệu USD của vua YouTube MrBeast](https://cdn.kienthuc.net.vn/images/190e30c7c04ee6e7103089027c41b3a9e1b34134f787801c747eb219a460d7a58bf1d2f9272e973d1b5e7feea8ceab37/mr-2.png.avif)

![[GALLERY] Người dân khám phá triển lãm Quy hoạch Hà Nội tầm nhìn 100 năm](https://cdn.kienthuc.net.vn/images/9296f0377c64048406d89ea0c83995cb7bd1ee5fe98fc7610ae151034114b28fd07352fe3c94b6acd25294aaea75c8be/4-4486.jpg.avif)
![[GALLERY] OpenAI tung chip AI đầu tiên, chính thức giảm phụ thuộc NVIDIA](https://cdn.kienthuc.net.vn/images/190e30c7c04ee6e7103089027c41b3a93af7f6b40dd9a37d2dbda2371688f829355f3886755cbc2560cedacf1cac977b/chip-2.png.avif)
![[GALLERY] Chi tiết xe bán tải địa hình Chery Jetour Zongheng F700 PHEV mới](https://cdn.kienthuc.net.vn/images/9296f0377c64048406d89ea0c83995cbaa2f09cb5010a93da44658e5ded0d5cce4f6b905bd8538085c16f74919f8d81d/1-5965.jpg.avif)
![[GALLERY] Máy sấy tóc thế hệ mới, cuộc đua công nghệ đầy bất ngờ](https://cdn.kienthuc.net.vn/images/190e30c7c04ee6e7103089027c41b3a909b78456dd2461b6cb47d3b262861af23b85f23f7e16344dbb076f1cd17b2a90/thi-3.png.avif)
![[GALLERY] "Soi" Mazda Flair Crossover 2027 - SUV hình hộp chỉ 320 triệu đồng](https://cdn.kienthuc.net.vn/images/9296f0377c64048406d89ea0c83995cbaa2f09cb5010a93da44658e5ded0d5ccf378db055131ca8d65d6707eaecd8e16/1-8095.jpg.avif)
![[GALLERY] Threads không còn 'vùng trống', nội dung vi phạm sẽ bị gỡ](https://cdn.kienthuc.net.vn/images/190e30c7c04ee6e7103089027c41b3a93c9d5dcf5468e397f60b455fba7d80707e189fb8696dcdd9118ba6b11a6c0449/th-11.png.avif)

Theo quy định mới nhất của Chính phủ từ 1/7/2026, ôtô tải pickup cabin kép và xe tải Van có khối lượng toàn bộ dưới 3.500kg được tổ chức giao thông như ôtô con.

![[GALLERY] Chi tiết xe bán tải địa hình Chery Jetour Zongheng F700 PHEV mới](https://cdn.kienthuc.net.vn/images/fa6fa22794e1049e63e79fd6d1d3f051aa2f09cb5010a93da44658e5ded0d5cce4f6b905bd8538085c16f74919f8d81d/1-5965.jpg.avif)
![[GALLERY] "Soi" Mazda Flair Crossover 2027 - SUV hình hộp chỉ 320 triệu đồng](https://cdn.kienthuc.net.vn/images/fa6fa22794e1049e63e79fd6d1d3f051aa2f09cb5010a93da44658e5ded0d5ccf378db055131ca8d65d6707eaecd8e16/1-8095.jpg.avif)

![[GALLERY] Sốc với doanh thu 300 triệu USD của vua YouTube MrBeast](https://cdn.kienthuc.net.vn/images/fc6b1457645b26575fcbba0a62d9d7d4e1b34134f787801c747eb219a460d7a58bf1d2f9272e973d1b5e7feea8ceab37/mr-2.png.avif)
MrBeast tiếp tục gây choáng khi đạt doanh thu 300 triệu USD trong một năm, dẫn đầu bảng xếp hạng creator của Forbes và bỏ xa mọi đối thủ.

Ấm siêu tốc giúp đun nước nhanh nhưng nhiều thói quen sử dụng sai cách lại khiến hóa đơn tiền điện tăng và làm giảm đáng kể tuổi thọ của thiết bị.
![[GALLERY] Người dân khám phá triển lãm Quy hoạch Hà Nội tầm nhìn 100 năm](https://cdn.kienthuc.net.vn/images/fa6fa22794e1049e63e79fd6d1d3f0517bd1ee5fe98fc7610ae151034114b28fd07352fe3c94b6acd25294aaea75c8be/4-4486.jpg.avif)
Triển lãm Quy hoạch Hà Nội tầm nhìn 100 năm thu hút hàng nghìn người dân, du khách đến tham quan, trải nghiệm và tìm hiểu diện mạo Hà Nội trong tương lai.
![[GALLERY] OpenAI tung chip AI đầu tiên, chính thức giảm phụ thuộc NVIDIA](https://cdn.kienthuc.net.vn/images/fc6b1457645b26575fcbba0a62d9d7d43af7f6b40dd9a37d2dbda2371688f829355f3886755cbc2560cedacf1cac977b/chip-2.png.avif)
OpenAI ra mắt chip AI Jalapeño sau 9 tháng phát triển bằng chính AI, mở đầu chiến lược giảm phụ thuộc NVIDIA và cắt mạnh chi phí vận hành.
![[GALLERY] Chi tiết xe bán tải địa hình Chery Jetour Zongheng F700 PHEV mới](https://cdn.kienthuc.net.vn/images/fa6fa22794e1049e63e79fd6d1d3f051aa2f09cb5010a93da44658e5ded0d5cce4f6b905bd8538085c16f74919f8d81d/1-5965.jpg.avif)
Chery Jetour Zongheng F700 PHEV là mẫu bán tải thiết kế dựa một phần trên phiên bản SUV G700 của năm ngoái, phạm vi hoạt động 1300km và hiệu suất nhiệt 45,5%.
![[GALLERY] Máy sấy tóc thế hệ mới, cuộc đua công nghệ đầy bất ngờ](https://cdn.kienthuc.net.vn/images/fc6b1457645b26575fcbba0a62d9d7d409b78456dd2461b6cb47d3b262861af23b85f23f7e16344dbb076f1cd17b2a90/thi-3.png.avif)
Máy sấy tóc không còn chỉ để làm khô mà đang trở thành trợ thủ chăm sóc tóc thông minh với cảm biến nhiệt, ion âm và tạo kiểu đa năng.
![[GALLERY] "Soi" Mazda Flair Crossover 2027 - SUV hình hộp chỉ 320 triệu đồng](https://cdn.kienthuc.net.vn/images/fa6fa22794e1049e63e79fd6d1d3f051aa2f09cb5010a93da44658e5ded0d5ccf378db055131ca8d65d6707eaecd8e16/1-8095.jpg.avif)
Mẫu xe Mazda Flair Crossover 2027 thế hệ mới vừa trình làng ở thị trường Nhật Bản với ngoại thất thay đổi nhẹ nhưng trang bị an toàn lại nâng cấp đáng kể.
![[GALLERY] Threads không còn 'vùng trống', nội dung vi phạm sẽ bị gỡ](https://cdn.kienthuc.net.vn/images/fc6b1457645b26575fcbba0a62d9d7d43c9d5dcf5468e397f60b455fba7d80707e189fb8696dcdd9118ba6b11a6c0449/th-11.png.avif)
Lần đầu tiên Meta thực hiện yêu cầu gỡ nội dung vi phạm trên Threads tại Việt Nam, đánh dấu bước thay đổi quan trọng trong quản lý nền tảng này.
![[GALLERY] Bóc trần 'nông trại AI' ở Việt Nam, lừa đảo xuyên biên giới](https://cdn.kienthuc.net.vn/images/fc6b1457645b26575fcbba0a62d9d7d41a1d6db971fe1c4ae9cffbf2fe79fc63ddf319af6069c593c70f7a5a4968554f/nhan-5.png.avif)
AI mã nguồn mở đang bị biến thành công cụ tạo tin giả, giúp các "nông trại click" vượt rào cản ngôn ngữ để lừa đảo người dùng tại Bắc Âu.
![[GALLERY] Tên lửa Patriot PAC-2 GEM-T mảnh ghép lợi hại của Patriot](https://cdn.kienthuc.net.vn/images/8366023e10990871ea1458fbe73c9bf16ae27530fb2008ee7a6027e8782f6a33b07a64ce5987a44b638f9bb8eaceecc952a1e791860c9cc172d5cfe792c4adeb5efd9e188d27e1d2a0087bd7e64ebc399194220b78a680068e09e9939d42e9a8d84fa7871eb0f302634d540e142d240d088947e84f80275d5dc1fc397d394dc6/ba-lan-chi-gan-1-ty-usd-nang-cap-he-thong-patriot-pac-2-gem-t-la-sat-thu-gi-2291.jpg.avif)
Tên lửa PAC-2 GEM-T biến hệ thống Patriot thành lá chắn thép tầm xa, sẵn sàng quét sạch mọi mục tiêu từ 150km.
![[GALLERY] AI Claude gây chấn động, xâm nhập hệ thống mật NSA trong vài giờ?](https://cdn.kienthuc.net.vn/images/fc6b1457645b26575fcbba0a62d9d7d47032843b5e7701179fcac1f3d80668d08bf1d2f9272e973d1b5e7feea8ceab37/cl-2.png.avif)
Thông tin Claude Mythos 5 tự xâm nhập gần như toàn bộ hệ thống mật của NSA khiến giới công nghệ và an ninh Mỹ rúng động.
![[GALLERY] Mục sở thị Suzuki Address 125 2026 vừa "lột xác", hơn 45 triệu đồng](https://cdn.kienthuc.net.vn/images/fa6fa22794e1049e63e79fd6d1d3f051aa2f09cb5010a93da44658e5ded0d5ccf839fa0580d73d8bcf911c9db75bd092/2-828.jpg.avif)
Suzuki Address 125 phiên bản 2026 vừa chính thức ra mắt tại thị trường Nhật Bản. Xe có giá bán ở mức 280.500 yên (tương đương khoảng 45,6 triệu đồng).

Khi nhà nhà còn say giấc, những người hái rau đọt choại đã lội bùn, băng sậy để mưu sinh. Công việc tưởng chừng đơn giản nhưng ẩn chứa nhiều vất vả, hiểm nguy.
![[GALLERY] iPhone 18 Pro có gì hot? 4 nâng cấp khiến iFan khó cưỡng](https://cdn.kienthuc.net.vn/images/fc6b1457645b26575fcbba0a62d9d7d4c84d65754469bfb68566678d962d188dbaf95a50518cc744c6184e1388024d95/ip-1.png.avif)
Chip A20 Pro 2nm, camera đột phá, modem C2 và mức giá dễ chịu là 4 điểm sáng được kỳ vọng sẽ giúp iPhone 18 Pro tạo cơn sốt mới.
![[GALLERY] Cận cảnh Haval GWM H10 dài tới 5,3 mét "quyết đấu" Lynk & Co 900](https://cdn.kienthuc.net.vn/images/fa6fa22794e1049e63e79fd6d1d3f051aa2f09cb5010a93da44658e5ded0d5ccf00d874b7073d9f7d3a51e6c8794b6e7/2-7625.jpg.avif)
Haval GWM H10 dài 5,3 mét đã chính thức ra mắt tại Trung Quốc, đây là mẫu SUV hybrid cắm điện cạnh tranh với các đối thủ đồng hương Lynk & Co 900.

Xem tử vi hàng ngày, tử vi 12 con giáp hôm nay cho thấy tuổi Sửu có sự nghiệp đầy triển vọng và có thể nhận được tin vui về tiền bạc.
![[GALLERY] Ra mắt siêu xe McLaren Artura 1000GP đặc biệt, giới hạn 10 chiếc](https://cdn.kienthuc.net.vn/images/fa6fa22794e1049e63e79fd6d1d3f051aa2f09cb5010a93da44658e5ded0d5cc36c8feef0d0f97ba8df248b05ec79719/1.jpg.avif)
Chỉ có 10 chiếc McLaren Artura 1000GP được sản xuất để kỷ niệm 1.000 lần tham gia vào Công thức 1, với ngoại thất lấy cảm hứng từ chiếc xe F1 mà hãng đang đua.
![[GALLERY] TikTok tung Mini Game, Mini Drama giữ chân người dùng](https://cdn.kienthuc.net.vn/images/fc6b1457645b26575fcbba0a62d9d7d4473ad679d748c2fb9f3350dcbae54db92ab1a577eeec98cc2db43b1142d56cd8/tik-7.png.avif)
TikTok ra mắt Mini Game và Mini Drama tích hợp ngay trong ứng dụng, cho phép xem phim, chơi game, thanh toán không cần rời nền tảng.
![[GALLERY] Ferrari Luce bị "giang cư dân" chê tơi tả, nhưng vẫn cháy hàng](https://cdn.kienthuc.net.vn/images/fa6fa22794e1049e63e79fd6d1d3f051aa2f09cb5010a93da44658e5ded0d5cc42b1d3171f69d28355016de4e9a7c204/11-4571.jpg.avif)
Ferrari chỉ bán ra 88 chiếc Ferrari Luce cho thị trường Trung Quốc. Dù bị cư dân mạng chê tơi tả nhưng Luce vẫn cháy hàng ngay lập tức ở thị trường tỷ dân.
![[GALLERY] Tiếng "lách tách" bàn phím cơ, âm thanh đánh thức cả tuổi trẻ](https://cdn.kienthuc.net.vn/images/fc6b1457645b26575fcbba0a62d9d7d470872e353e15197d5c0f51bd1690bf0c83a26788e95d097b0f332403453a42ce/ban-4.png.avif)
Từ chuột bi Mitsumi, bàn phím cao su đến bàn phím cơ hiện đại, hành trình của game thủ cũng là ký ức tuổi trẻ khiến nhiều người đàn ông bồi hồi.